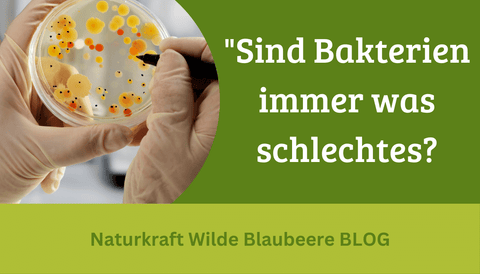

Dear friends of chronic health,
Frustration, anger, upset...to the point of depression
.. many parents describe their children's state of mind to me in much greater detail. Especially in the last two years.
They often sound desperate and don't really know how to deal with it.
Of course, this is a multifaceted issue and should be addressed from all sides. Most importantly, show TRUST in your loved ones; whether big or small. You notice that you are being recognized and taken seriously .
Fear and a lack of self-confidence often lie behind all these supposedly negative emotions. Ask your loved ones why and what are you afraid of?
How can we support the mood?
In addition to an optimal need for vital substances, exercise, fresh air and love for what we do, there is also support from nature.
In fact, there are several studies that have been evaluated in young adults and children.
In the 2017 issue of Nutrients magazine, I came across a study that was conducted on this topic with children and young adults. They wanted the effect of the valuable blueberry flavonoids test.
Mood status was evaluated before and after drinking blueberry juice. And...it was "just" blueberry juice. Just think how it would have turned out with an extract.
 tested blueberry extracts HERE
tested blueberry extracts HERE
The mood is improving!
The most important thing: the mood improved demonstrably in all age groups. See, it works.
I wish you many laughing moments so that your immune system cheers day after day.
PS: my insider tip: when I'm in a bad mood, I secretly snack on my beloved Blueantox-kids. T he gummy drops are just heavenly.
Yours and yours Jutta Suffner and the blueberry team